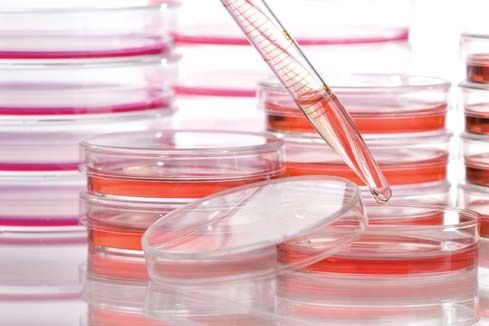

About of Tutumi Tutumi Bio-tech!
Tutumi Biotech Private Limited (henceforth referred as ‘Tutumi’) was established in Mumbai on 14th June 2023. We, a group of like-minded professionals and entrepreneurs have formed this company with a view to address problems in the field of healthcare and social cause for human being as well as animals.
Tutumi Biotech Pvt Ltd aims at discovering, inventing, developing, manufacturing and otherwise dealing in various traditional and modern healthcare products, processes and devices to improve the lives of humans and animals.
Tutumi is a dream of five like-minded experts from different field for better health of all.
Contact us
The snake venom per se is being used as therapeutics in cardiac disorders, as an anti-aging agent, anti-cancer agent, painkiller, etc. Although its therapeutic applications are being explored world-wide, it is not done in India. The snakes are key players in maintaining the ecological balance especially in agricultural dominant areas. They maintain a healthy balanced ecosystem, which is beneficial for the existence of human life. Hence, snake welfare and safety is our utmost priority.
Here, we propose to establish India’s first ever ‘Snake Venom Repository and R & D Centre’ in Maharashtra for collection of venom, for doing detailed snake Venom Mapping, for research, for training snake rescuers and for reducing human-snake conflict by creating awareness.
Contact Us



